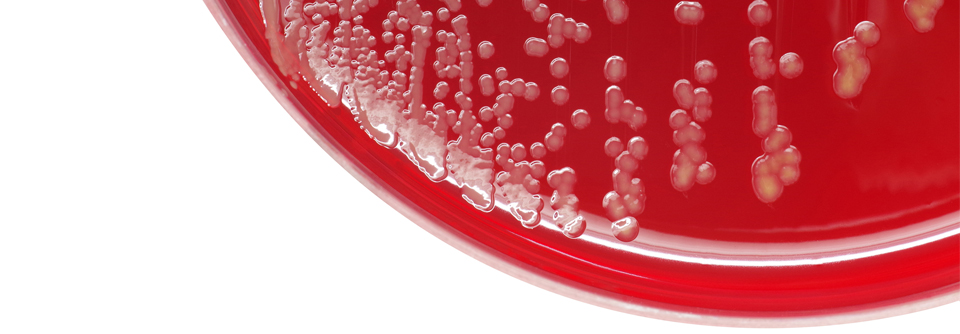

Atopische Dermatitis Basispflege und gezielte Therapien besänftigen gereizte Haut
 Mit einer guten Basistherapie kann man bereits einiges bei Kindern mit Neurodermitis erreichen.
© Julia – stock.adobe.com
Mit einer guten Basistherapie kann man bereits einiges bei Kindern mit Neurodermitis erreichen.
© Julia – stock.adobe.com
Exazerbationen vermeiden und Läsionen rasch zum Abheilen bringen – das ist das Ziel bei der Therapie von atopischer Dermatitis. Bei leichter Erkrankung reicht die topische Behandlung aus, Patienten mit mittelschwerem bis schwerem Verlauf benötigen eine systemische Therapie, erklärt Prof. Dr. Dietrich Abeck vom Hautzentrum Nymphenburg in München. Als wichtige therapeutische Angriffspunkte nennt er:
- eine gestörte Hautbarriere mit erhöhtem Wasserverlust
- Vorherrschen von Staphylococcus aureus im Mikrobiom
- Typ-2-dominante Reaktionen mit immunologischen Veränderungen
Von zentraler Bedeutung ist die dauerhaft durchgeführte und individuell angepasste Basistherapie. Sie vermag die…
Liebe Leserin, lieber Leser, aus rechtlichen Gründen ist der Beitrag, den Sie aufrufen möchten, nur für medizinische Fachkreise zugänglich. Wenn Sie diesen Fachkreisen angehören (Ärzte, Apotheker, Medizinstudenten, medizinisches Fachpersonal, Mitarbeiter der pharmazeutischen oder medizintechnischen Industrie, Fachjournalisten), loggen Sie sich bitte ein oder registrieren sich auf unserer Seite. Der Zugang ist kostenlos.
Benutzeranmeldung
Bitte geben Sie Ihren Benutzernamen und Ihr Passwort ein, um sich an der Website anzumelden.
Bei Fragen zur Anmeldung senden Sie bitte eine Mail an online@medical-tribune.de.